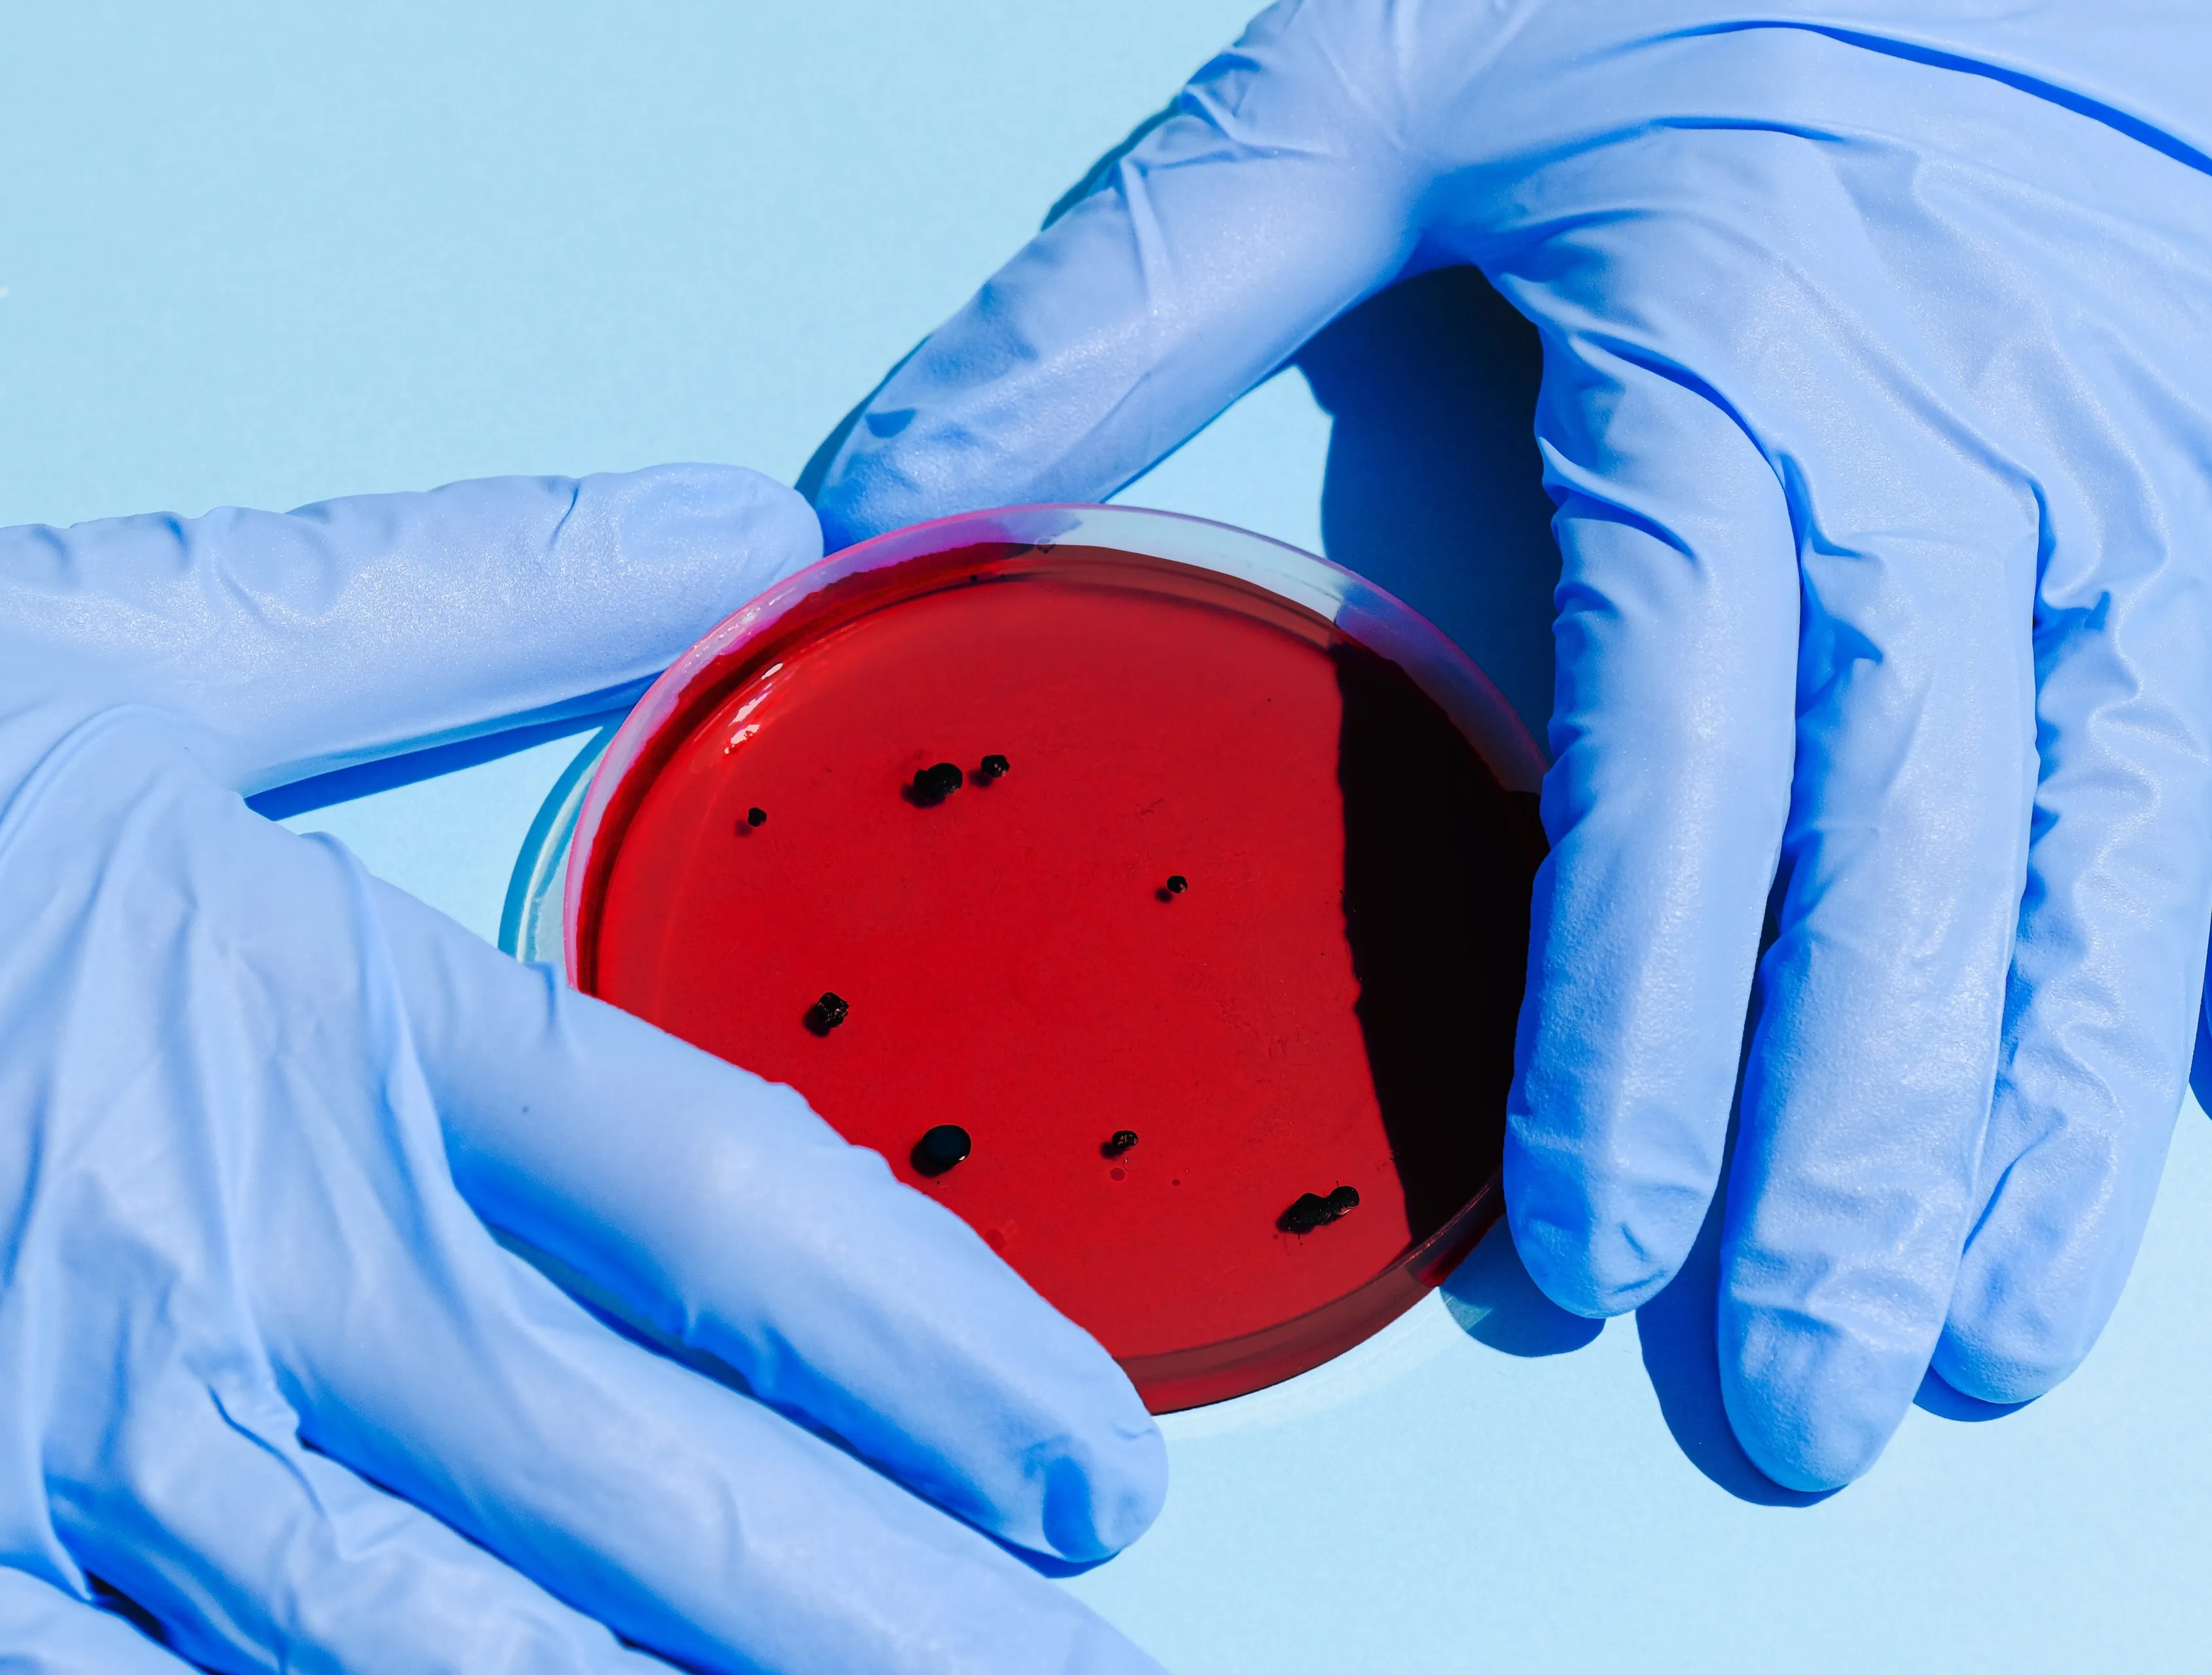
pexels anna shvets 3786217 e1602085115583

Gratis 'teststraat' coronavirus in Denekamp van start
07 okt 2020, 17:39 • Politiek
CC0
De testlocatie aan de Voltaweg in Denekamp, waar het mogelijk een coronatest te krijgen, is van start gegaan.
De initiatiefnemers Adam Kok en Dennis Olde Riekerink hebben hier in samenwerking met de GGD en met steun van de gemeente Dinkelland aan gewerkt.
De teststraat komt als locatie in het overzicht bij de GGD te staan. Dat betekent dat een ieder die zich aanmeld voor een coronatest deze locatie, mits er plek is, uit kan kiezen.
Een deel van de plekken die de locatie kan bieden worden bewaard voor Dinkellanders. “Een heel mooi initiatief van de heren”, geeft burgemeester Joosten van de gemeente Dinkelland enthousiast aan. “Dat we op deze manier een extra testlocatie voor onze inwoners kunnen bieden is natuurlijk hartstikke mooi. Inwoners met corona gerelateerde klachten moeten zich kunnen laten testen en daarvoor niet zo ver hoeven reizen. Met deze testlocatie komen we in die vraag tegemoet.”
Eigen website voor gratis afspraak
Inwoners in Dinkelland kunnen via de website www.teststraatdinkelland.nl
een afspraak maken voor een coronatest. Afspraken kunnen van 08.00 tot 11.00 uur worden ingepland.
“De testen zijn helemaal gratis”, geeft de Denekampse apotheker Adam Kok aan. “Dat is wel belangrijk om te benoemen. Het gaat net zoals een gewone GGD-teststraat in zijn werk, alleen bewaren we wat plaatsen voor inwoners uit Dinkelland.”
De verwachting is dat de uitslagen vlot gegeven kunnen worden. “We streven naar een uitslag binnen 24 uur. De uitslagen zijn het snelst online in te zien door in te loggen met een Digid. Als iemand dat niet zelf doet, dan neemt de GGD contact op.” Dat kan tot 48 uur duren.
Loading articles...
Loading


